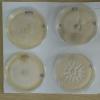
message #60614
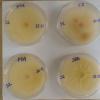
message #60614
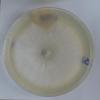
message #60614

06-04-2026 21:36
Viktorie Halasu
Hello, could anyone please send me the article wi
06-04-2026 19:40
Help with this one much appreciated, on rotting Fa
06-04-2026 11:07
Louis DENYBonjour forum, Trouvé sur bois de feuillu très d
06-04-2026 16:24
Juuso ÄikäsLast Tuesday I found some tiny white Helotiales gr
05-04-2026 20:40
Robin Isaksson
Hi!Found i Japan on bark of Abies sp. Spores 35-4
06-04-2026 08:15
Lothar Krieglsteiner
some days ago, on the lower surface of leaf of Que
Aspergillus sect. fumigati
Stephen Martin Mifsud,
26-12-2019 16:05
I was trying to recultivate a species of Talaromyces growing on Washingtonia seeds fallen on the soil. The seeds and specimen was dried at room temp. Months later, I tried to recultivate the Talaromyces from the seed husks, kernels, etc and I got instead a range of interesting microfungi including three Aspergillus sp.One of them formed white colonies, fast growing at 24C but on a closer look they had few grey-green conidiophores with shortly columnar conidial heads. The Vesicles were subglobular, 10-18um wide, with one series phialides about 6um long, emerging from about 2/3 of the vesicle (not fully radiating). Conidia in dense inticated chains forming 50-80um columnar or subglobose heads, each conidiospore 2.5um, sphereical, greyish-green. Conidiophores smooth, 60-120um long, 5-7um wide, somewhat expanding below the vesicle (but not always),
Also present where clesitotheca producing hundreds of globulae asci holding 8 ascospores. There where about 5-6um wide with their characteristical two radial wings and what I think to have seen under x1000 oil immersion, spines or warts on the dorsal/ventral side.
With the data available, I have thought the species is Aspergillus sect. fumigati, and despite not having an electron microcope to see the ornamentation of the ascospores, I think the warted surfaces and other characters collectively lead to the species pseudofisheri.
The colonies on OAT, PDA, CZ and MEA where overall white (much more green in A. fischeri)